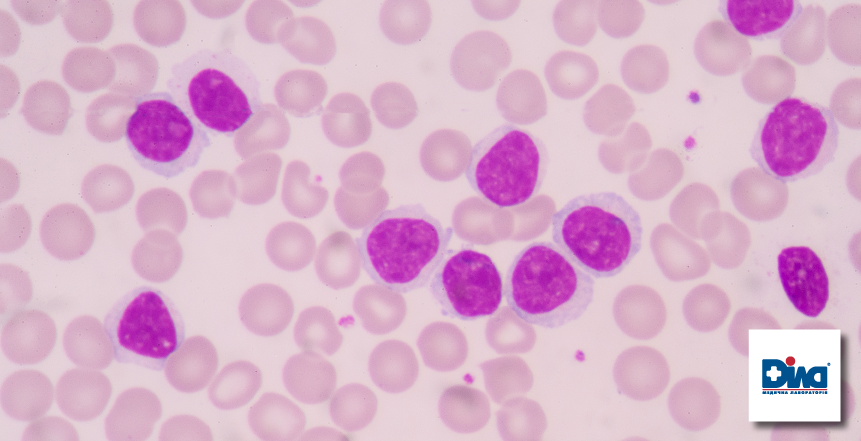
Фото - Лабораторное исследование онкогематологического профиля

Лабораторное исследование онкогематологического профиля
30.11.2021
С 15.05.21 медицинская лаборатория «Дила» актуализирует продуктовый портфель «Онкогематолгия». Теперь у Вас есть возможность осуществить качественное, достоверное, точное и быстрое лабораторное обследование онкогематологического профиля согласно международных стандартов. Данная статья ностит обзорный характер и приследует цель рассмотреть определенные приемущества и особенности упомянутого выше обследования.
Установка диагноза в онкогематологической практике опирается на специальную лабораторную диагностику – соединение методов морфологии, имунофенотипирования, цитохимических, молекулярных и цитогенетических. Указанные методы используются в определенном объёме и последовательности в зависимости от клинической ситуации. Морфологическое исследование является базовым и необходимым, оно подтверждает присутствие субстратных опухолевых клеток в биологическом материале. Качественно выполненное морфологическое исследование является основанием для последующих более сложных и длительных исследований. Например, если по данным миелограммы в костном мозге опухолевые клетки отсутствуют, то нет необходимости выполнять иммунофенотипирование, цитогенетические или молекулярно-генетическое исследования. Это позволяет избежать лишних усилий, трат и сохранить время, что очень важно в условиях диагностики ургентных пациентов.
Только определенная ступенчатая последовательность и комплексность исследований могут обеспечить достоверную лабораторную диагностику согласно международным стандартам NCCN, ESMO. Мы предлагаем исследования, которые удобно объединены в пакеты или комплексы по два и более. Именно комплексность является особенностью продуктового портфеля «Онкогематология» и удачно выделяет нашу лабораторию среди других предложений.

Во всем мире лабораторная диагностика онкогематологических заболеваний – задание повышенной сложности и требует:
- Использования проверенных алгоритмов согласно международным стандартам
- Использование оборудования, которое отвечает современным стандартам
- Глубокого профессионального опыта врача узкого онкогематологического профиля
Медицинская лаборатория «Дила» удачно объединяет все эти требования.
I. Если врач стремиться установить диагноз согласно международным стандартам, возникает необходимость в использовании стандартизованных, унифицированных во всем мире методик и алгоритмов. Медицинская лаборатория «Дила» получила специализированный аттестат про аккредитацию исключительно для медицинских лабораторий– ДСТУ ISO 15189 и успешно работает согласно с этим стандартом.
В онкогематологической практике для использования стандартных нозологий МКХ-Онкология (2016) на ряду со стандартами других диагностических направлений, необходимо использовать международные алгоритмы специальной лабораторной диагностики. Это можно ярко продемонстрировать на примере определения фенотипа опухоли, которое является одним из базовых методов диагностики.
Иммунофенотипирование – это аналитический процесс определения типа и степени экспрессии клетками отдельных маркеров, т.н. СD-кластеров дифференциирования (мембранных и внутриклеточных), характерных для определенной линии кроветворения. Проточная цитофлюориметрия – метод иммунофенотипирования клеточных суспензий.
В нашей лаборатории подход к иммунофенотипированию опухолевых клеток основан на использовании стандартного пошагового алгоритма консорциума EuroFlow, который был основан в 2005 году и охватывает 20 исследовательских групп из 11 стран мира. Целью является обновление и стандартизация проточной цитометриии, которые ведут к глобальному усовершенствованию и прогрессу в диагностике онкогематологических заболеваний.

Согласно с указанным алгоритмом, иммунофенотипирование проводится с использованием 10-12-цветных панелей антител, что позволяет идентифицировать и полностью охарактеризовать клонально расширенные популяции патологических клеток и сделать выводы про соответствие полученного фенотипа определенной патологии согласно ВООЗ (последняя версия WHO-O 2016 года). Это приобретает особое значение во время оценки ответа на лечение (Response Criteria) согласно с действующими международными протоколами. Для мониторинга резистентного пула опухолевых клеток (MRD) во время и после терапии используются специальные высокочувствительные протоколы детекции малоклеточной популяции на фоне регенерирующего гемопоэза. Такая проточная цитометрия называется NGF (Next Generation Flow). Чувствительность метода составляет минимум 1 на 10 в 5 степени ядросодержащих клеток.
Упомянутые протоколы позволяют разграничить нормальные клетки (гематогоны) и остаточную популяцию клеток с опухолевым фенотипом. Иммунофенотипирование методом проточной цитометрии предложено в комплексе с предидущим цитоморфологическим исследованием.
II. Медицинская лаборатория «Дила» использует новое оборудование от известных производителей согласно международным стандартам. Непосредственно для выполнения фенотипирования опухолевых клеток согласно с алгоритмом консорциума EuroFlow используется прибор нового поколения BD FACSLyric, который объединяет в себе высокую чувствительность, простоту, скорость, автоматизацию для облегчения рабочего процесса и повышения продуктивности. Оборудованный 3 лазерами (синим, красным и фиолетовым), 12 каналами флуоресценции, 10 цветами, прибор полностью соответствует высоким стандартам консорциума EuroFlow, обеспечивает стандартизацию и сотрудничество с любыми диагностическими центрами мира благодаря точным результатам и уникальным возможностям переноса результатов анализов.

III. Кроме соблюдения высоких международных стандартов для качественной диагностики онкогематологических заболеваний нужен глубокий профессиональный опыт врача узкой специализации. В Украине и во всем мире таких опытных профессионалов, которые могут точно и достоверно выполнять специальные лабораторные исследования – единицы. Наши експерты – это команда признанных профессионалов в диагностике онкогематологических заболеваний. Они регулярно посещяют курсы повышения квалификации украинских и зарубежных учебных центров, больших европейских лабораторий Швеции, Испании, Франции.
Кроме того, медицинская лаборатория «Дила» имеет статус клинической базы кафедры клинической имунологии и аллергологии НМАПО им. П.Л. Шупика, принимает участие в международных клинических исследованиях.
Молекулярные и цитогенетические исследования.
Особое внимание следует уделить молекулярно-биологическим и цитогенетическим исследованиям во время диагностики онкогематологических заболеваний.
На сегодняшний день ведущее место среди теорий лекомогенеза занимает молекулярно-генетическая теория, согласно с которой в основе злокачественной трансформации лежат структурно-функциональные изменения клеточных генов. Малигнизация нормальной клетки является результатом каскадного накопления определенных изменений в генетическом материале. Следовательно, злокачественная опухоль – это генетическое заболевание с фенотипической и морфофункциональной гетерогенностью. Как упоминалсь выше, в 2016 году классификация онкогематологических новообразований была пересмотрена и дополнена с учетом обнаруженных уникальных биомаркеров, ассоциированными с определенными нозологическими формами. В частности, это касается мутационного статуса и уровня экспресии генов. Поэтому особую актуальность в лабораторной диагностике злокачественных опухолей системы гемостаза приобретают приобретает взвешенное обединение методов иммунофенотипирования, морфологии, цитохимии с методами цитогенетики и молекулярной биологии. Как правило, используют FISH-анализ с локус специфичными ДНК-зондами и метод ПЦР (PCR), для более точной диагностики – кариотипирование.
Интенсивность экспрессии генов коррелирует с колличеством опухолевых клеток, что позволяет определить степень первичного опухолевого поражения и провести мониторинг опухолевой массы для оценки эффективности лечения. Характер мутаций обусловливает уровень поражения гемопоэтической клетки (уровень блокирования её дифферинциирования), определяет морфоцитохимические особенности и иммунофенотип опухолевых клеток. Наличие той либо иной аномалии кариотипа позволяет судить про степень злокачественности опухоли и прогнозировать эффективность терапии. Ранжирование больных онкогематологическими заболеваниями на группы благоприятных, промежуточных и неблагоприятных характеристик прогноза определяет тактику лечения. Выявление определенных молекулярно-генетических маркеров опухолевых бластных клеток является первым шагом к таргетной терапии онкогематологических заболеваний и проведению дифференциированного лечения в зависимости от группы риска. Примерами успешной таргетной терапии острого лейкоза является применение препаратов трансретиноевой кислоты при остром промиелоцитарном лейкозе, ингибиторов тирозинкиназы с полихимиотерапией при Ph+остром миелолейкозе и другое.
Генетические маркеры наряду с морфологическими, иммунологическими, цитохимическими характеристиками опухоли, а также клиническими данными используются в качестве критериев, которые позволяют выделить различные формы заболевания.
В частности лейкоз с t (12; 21) (p13; q22) TEL-AML1 (ETV6-RUNX1) – группа благоприятного прогноза. Частота полных ремиссий достигает 90%, а безрецидивная 5-летняя выживаемость больше 80%. При остром миелолейкозе с t (8; 21) (q22; q22) в результате транслокации происходит слияние гена AML1-ETO на хромосоме 8. В процессе лечения уровень химерного гена уменьшается на несколько порядков и соответственно увеличивается перед рецидивом. При промиелоцитарном лейкозе в транслокацию включен ген PML, который кодирует транскрипционный фактор на хромосоме 15 и RАRА-ген, который кодирует альфа-рецептор ретиноевой кислоты на хромосоме 17. Химерный белок PML/RARA обусловливает блок клеточного дифференциирования и высокую чувствительность опухолевых клеток к ретиноевой кислоте (ATRA). Наявность FLT3-ITD мутаций у больных ОМЛ, в виде единой генетической аберрации либо с другими мутациями, значительно снижает показатели безрецидивной и общей выживаемости. Наоборот, определение мутации в гене NPM1 либо гене CEBPA при отсутствии мутации FLT3-ITD ассоциируется с более благоприятным прогнозом. Перестройка гена JAK-2 вызывает немедленную активацию сигнального пути JAK-STAT. Патологическая передача сигналов JAK-STAT может быть нейтрализована при помощи JAK-ингибиторов.
Комплексная оценка прогностических факторов, включая молекулярно-генетические позволяет максимально точно стратифицировать группы риска пациентов с острым лейкозом и прогнозировать течение лейкемического процесса, что может служить основой для оптимизации индивидуализированного подхода к терапии с целью увеличения длительности и увеличения качества жизни пациентов.
В случае В-ХЛЛ, определение делеции del 17р13 и/или мутации ТР53, мутационного статуса генов IgHV позволяет выделить группу пациентов (около 10%), которым противопоказано лечение по стандартным схемам химио-иммунотерапии, потому что такое лечение способствует увеличению резистентности опухоли. Средняя продолжительность жизни у таких больных в случае получения стандартных схем не превышает 11 месяцев. Потому для больных с делецией 17 хромосомы схемой выбора терапии первой линии будет одна из таких без применения химиопрепаратов.
При множественной миеломе определение t(4;14)(q13;q32), t(14;16) (q32.3;q23), del 1p32, del 17p13 позволяет прогнозировать течение заболевания и длительность жизни больного, выбрать адекватную тактику ведения больного, тактику и схему лечения, определить, есть ли ответ на лечение и глубину этого ответа.
Медицинская лаборатория «Дила» предлагает удобный и качественный инструмент, который позволяет в полной мере использовать возможности комплексной специальной лабораторной диагностики в онкогематологической практике. Стандартизация и автоматизация позволяют быть уверенными в достоверности полученных результатов, а открытость, доброжелательность и высокий профессионализм наших сотрудников сделают процесс обследования максимально комфортным и превзойдут все ваши ожидания.